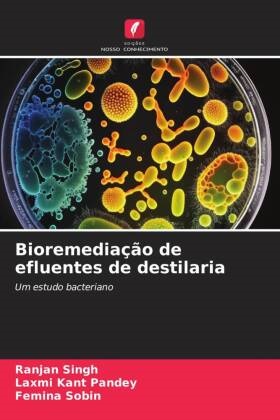

En savoir plus
A gestão dos resíduos é um problema global com o qual todo o mundo se debate atualmente. A composição e as características dos poluentes nos efluentes são desconhecidas, o que constitui a maior preocupação. A biorremediação é o método que utiliza a elevada e diversificada atividade metabólica dos microrganismos para decompor os contaminantes presentes nas águas residuais industriais, em particular nos efluentes das destilarias. A sua natureza facilmente disponível e o seu preço acessível fazem deles a opção preferida. A biorremediação é o processo de utilização de bactérias com forte atividade metabólica para decompor os contaminantes presentes nos efluentes industriais, nomeadamente nos efluentes das destilarias. Os microrganismos, isoladamente ou em conjunto com outros microrganismos, criam um ambiente propício não só à decomposição dos tóxicos mas também à produção de alguns subprodutos úteis. Este trabalho centra-se na bioremediação de efluentes de destilarias utilizando estirpes de bactérias. O livro é de interesse para estudantes, investigadores, professores ou qualquer pessoa interessada no tema.
A propos de l'auteur
O Dr. Ranjan Singh trabalha atualmente como Professor Assistente no Departamento de Botânica e Microbiologia, St. Aloysius College, Jabalpur, M.P., Índia. A sua área de interesse é a microbiologia aplicada. Tem 4 anos de experiência de ensino, 1,5 anos de experiência industrial e 6 anos de experiência de investigação. Publicou mais de 12 artigos e 6 livros.